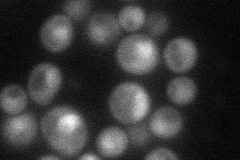
YIR011C
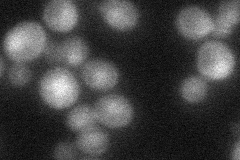
YIR011C
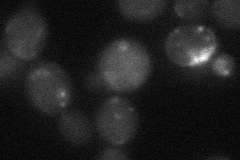
YIR011C

View description
Protein that interacts with the karyopherin Srp1p; may have a role with Srp1p in ubiquitin-mediated protein degradation
Localization:
Intensity:
Fold change:
Significance:
-
C’ GFP library in SD

nucleus24.93 -
N' NOP1pr-GFP in SD
cytosol,nucleus44.8423 -
N' TEF2pr-mCherry in SD

below threshold9.2763 -
N' NATIVEpr-GFP in SD
nucleus42.1185 -
N' TEF2pr-VC and Cyto-VN in SD
below threshold21.5645 -
C’ GFP library in SD+DTT

nucleus23.170.92No -
C’ GFP library in SD+H2O2

nucleus25.241.01No -
C’ GFP library in Starvation Media

nucleus18.390.73Yes -
C’ GFP library on the background of Pup2-DaMP

nucleus -
C’ GFP library on the background of CCT mutant

nucleus25.57251.02559No
